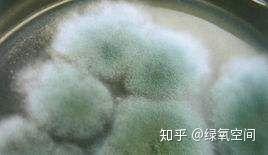
衣服长了霉点,衣服上长霉点是怎么回事

整理衣柜的时候,您会发现,压箱底的衣服拿出来会有一股霉味,您猜对啦,衣服上长霉菌了,味道就是霉菌散发出来的。除了味道,您还会留意到白色衣物衣领上有一圈黄渍,看着就恶心,心里是不是很想扔?衣服贵着咧。噢,很抓狂,有没有?
最最烦人的就是夏天穿的衣服,基本上过了这一季,下一季就得换新的。我问您为什么如此费钱?是因为衣服上的星星黑点,后背、肩膀都是,穿出去丢人呐?是的,衣服长霉菌确实很恼人,可小君有一些小妙招可以避免这些烦恼,咱们一起看看吧。

衣物上经常出现的“霉斑”,实际上就是微生物世界中最多彩的丝状真菌,称之为霉菌。分析衣物上的霉菌,可以辨认,衣领上的黄渍是“黄曲霉菌”、“球毛壳霉”,背上、肩膀上的黑点是“黑曲霉”。这些霉菌一旦赖在衣物上,使衣服发黑发黄,严重影响衣服的美观。同时霉菌还会产生多种毒素,危害人体健康,引发呼吸道疾病或是诱发过敏症状,严重的还可以致癌。

所谓知己知彼,百战不殆。想要断根除菌,就要对霉菌的产生有一个充分的了解,一般来说,霉菌生长需要两个主要条件,温度和湿度,20-30℃的温度和85%以上的相对湿度使他们的理想生活环境。在这样的条件下,只要有一个霉菌存在,它就能在一夜之间繁衍出无数辈后代。这就是为什么食物放在常温下容易发霉,放在冰箱里不容易发霉的道理。冰箱冷而干燥,能抑制霉菌的生长;室温暖而湿润,是霉菌栖身的良选之地。
了解霉菌的生长条件是为了了避免长霉菌,避免长霉菌需要控制衣服的温度和湿度。
1. 脏衣服不要堆放要晾挂
穿过的衣服会粘上人体的汗液、油脂、体温,这是微生物最喜欢的暖巢。如果换下的衣服不立即清洗,不要堆放,堆放的效应使体温聚集不易散,在汗水、油脂和体温的作用下,霉菌会不断繁衍生殖。这就是为什么堆放一晚上的脏衣服容易臭的原因,尤其是夏季的脏衣服更是一股酸臭味。正确的做法是,换下的衣服要通风晾挂,对流的空气可以快速吹干衣服,降低衣服的潮湿程度,如此细菌居然不容易滋生。
2、衣服要清洗干燥之后才能存放
清洗是为了断绝霉菌滋生的源头,没有父母,何来繁衍之说?清洗衣服重点部位,领口、袖口等,这两个地方是细菌的聚集地。除此之外,在洗涤的过程中务必将洗涤剂的残留物冲洗干净,否则也会引起霉菌出现。衣服洗干净之后还要晾干,衣服干燥细菌就没有滋生的条件。
3、衣柜要放防潮防虫剂
当然你会问,为什么存的时候是干净的干燥的,但一两个月后拿出来还会有味道?这个问题非常好,这是因为存放的条件在不知不觉中发生了改变。首先是温度、湿度的改变。存放的衣服一般都是折叠堆放,堆放必然保温,同时空气中的水分会以渗透的方式浸染衣服,养菌的场所自然就形成了。这个时候,一只小虫的入住或者空气里的细菌误入,霉菌就自然产生了。所以建议存放的衣柜需要放置防潮防虫剂。
4、存放的衣物要晾晒
北方冬天有一个习俗,冬季要勤晒被子。晒被子有两个好处,首先是冬季寒冷,被子晒太阳储存热量,夜里防寒;其次是为了防螨,被子盖在人体身上,容易沾上人体的汗液和油脂,多晒晒多通风以除螨。回过头来说存放的衣服,虽有防潮防虫剂,但还是不如定期通风晾晒。太阳是一款很好的除菌剂,简单又省钱。
如果衣服还是出现霉菌了,怎么办呢,几个妙招告诉您,这里采用对症下药的方法。
1、棉质或棉麻类衣服
推荐使用含有生物酶的氧清洗剂,它能够快速分解霉菌。其次,对于原色棉*衣麻**服的发霉情况,可将其暴晒;但彩色棉*衣麻**服则最好晾晒在通风处(暴晒容易掉色),等衣服干燥后用刷子刷掉霉斑,再行常规清洗。
2、 呢绒类
呢绒类衣服的发霉情况,建议用白布盖住衣服,再晒几个小时,等衣服干燥之后,用小刷子轻轻刷掉霉点。如果发霉得很严重,有长毛的情况,可以用毛巾沾上肥皂水擦拭,去污后用清水洗干净,晾干即可。
3、皮革类
皮革材料服装一般不用水洗,也不能暴晒(暴晒会引起衣服褪色或变花稍),稍沾湿的毛巾擦拭即可。晾干后,再涂上皮革护理油,保障皮革的使用时间。
4、 化纤织物
化纤衣服长霉斑用刷子蘸肥皂水在霉斑上擦洗几次(容易褪色的衣服要小心处理,肥皂容易使色牢度不高的衣服褪色),然后用清水冲洗,霉斑就可以消除。
或者把白醋倒进盆里,将霉斑衣服浸泡5分钟(让醋破坏霉菌),5分钟后,往盆里加一些温水,涂上肥皂,手动来回搓。再将擦洗过的化纤衣服浸泡在清水中,擦洗以去除霉斑。
5、 丝绸类
丝绸材料一般很贵,还特别容易破损,所以在清洗过程中不得使用蛮力。丝绸衣服先在水中亲拍,之后用手轻轻擦拭。霉点多、霉斑重的话,就在霉点上涂上5%的淡*水氨**,3~5分钟后洗干净,霉斑就会不见了。丝绸衣服上霉斑还有一个克星就是酒精,酒精可以破坏霉斑中霉菌,且不会破坏丝绸材质的衣服。但使用酒精需要注意的是,要将酒精稀释到50%的浓度,不能过高。酒精洒在衣服的霉斑上,让它静置一会儿,再擦洗一遍,最后用清水冲洗干净即可。

浏览文章之后,相信大家都很有收获。衣服长霉菌真是一件非常恼人的事情,不仅损害衣服的外观,还对人体有致病的伤害,不得不防。防止长霉的办法就是要控制衣服堆放的温度和湿度,即使长霉了也不要担忧,直接用小君的妙招对付就行啦。同时请大家注意啦,对于久放的衣物不要立即穿戴,一定要经过清洗晾晒之后才穿,如此才更干净舒服。
文章转至知乎绿氧空间